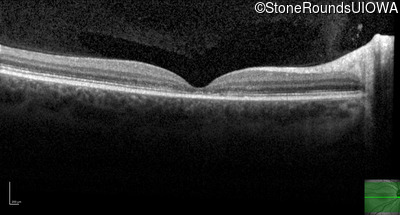
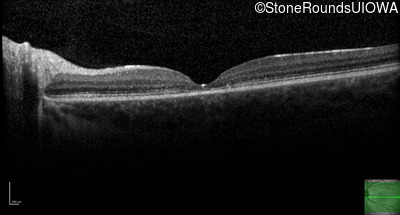
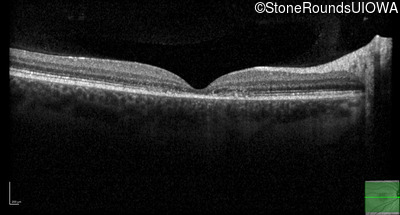
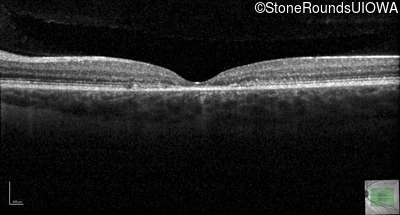

Case
SR1869
Student Mode
AR Stargardt Disease (IIA)
Female
Female
Hidden
SR1869
Student Mode
AR Stargardt Disease (IIA)
Female
Female
History
This 20 year old man first noticed some difficulty reading the board at school in 9th grade 20 in 2017
| Age at visit: 20 years |
| Age at visit: 22 years |
| OD | OS | ||
|---|---|---|---|
| OD | OS | ||
|---|---|---|---|
| OD | OS | ||
|---|---|---|---|
Diagnosis & molecular findings
| Disease | Gene | Allele 1 variant(s) | Allele 2 variant(s) | Inheritance mode |
|---|---|---|---|---|
| AR Stargardt Disease | ABCA4 | Gly607Arg GGG>AGG | Gly1961Glu GGA>GAA | AR |
Disease:
Gene:
Allele 1:
Gly607Arg GGG>AGG
Allele 2:
Gly1961Glu GGA>GAA
Inheritance:
AR